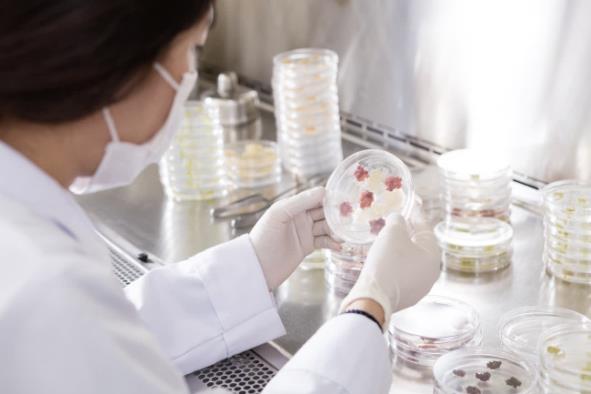

Our Science
Tell your brand's story through images.
At ClearLucent, we believe everyone deserves clear, glass-like skin. Our anti-aging regimen is designed for all skin types, developed with a deep understanding of skin needs. Our skincare range combines research, stem cell technology, and high-quality ingredients for a five-step regimen.

Advanced Stem Cell Technology
Utilizing advanced stem cell technology, our skincare products harness the power of unique plant-derived ingredients from Korea's Ulleungdo Island. These exclusive botanicals support skin regeneration and rejuvenation, effectively addressing the visible signs of aging.

Cellular Activator & Peptide
Our formulas contain numerous levels of Cellular Activators designed to improve skin hydration by supporting the Natural Moisturizing Factor (NMF), a critical component in maintaining a healthy skin barrier. This innovative ingredient ensures skin remains moisturized and supple, resulting in a youthful, glass-like complexion.
Unique Key Biomolecules Ingredients
Our products' efficacy is backed by various clinical studies. The MTT assay demonstrates the safety and effectiveness of our Cellular Activator, confirming its non-toxic nature and ability to support skin cell growth. Additionally, the PIP immunoenzyme assay showcases our products' ability to stimulate collagen production, a vital component in maintaining skin elasticity and reducing the appearance of fine lines and wrinkles.

Melanin Control for Brighter Skin
Uneven skin tone and hyperpigmentation can result from excessive melanin production. Our skincare line inhibits the activity of tyrosinase (TYR), a key enzyme responsible for melanin synthesis, and reduces the effects of alpha-melanin stimulating hormone (α-MSH), leading to brighter and more even-toned skin.

Comprehensive Skincare Solution
Our inclusive step-by-step daily skincare regimen, featuring our advanced stem cell technology and exclusive Korean botanicals, delivers visible results for all skin types. The combination of scientifically-proven ingredients ensures that everyone can achieve clear, glass-like skin.